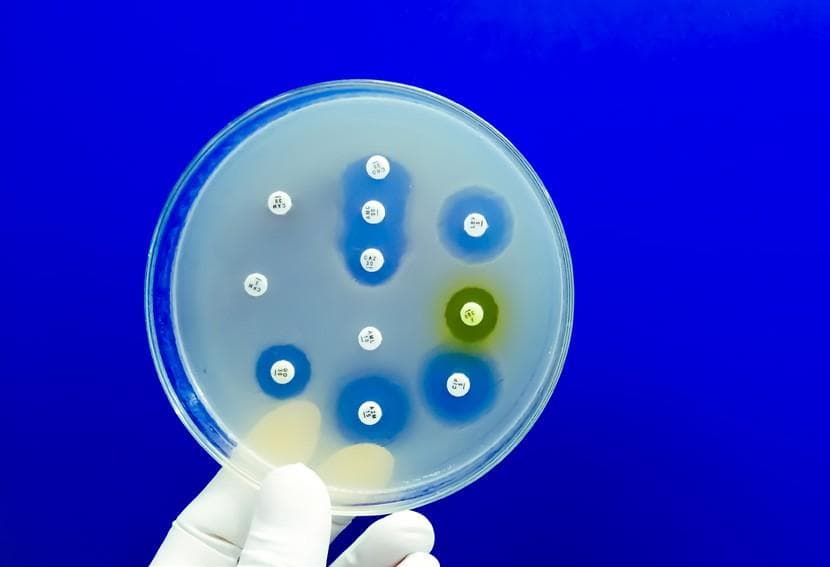
GSK invests £45m with Fleming Initiative to combat AMR

44 articles from this collection:

FDA approves Pfizer’s Beqvez for treatment of haemophilia B
Pfizer has announced that the FDA has approved Beqvez (fidanacogene elaparvovec-dzkt) for the treatment of adults with moderate-to-severe haemophilia B.

PharmaTimes
Www.pharmatimes.com/croy

Sanofi, Formation Bio and OpenAI announce new AI collaboration
Sanofi, Formation Bio and OpenAI have announced that they have entered into a collaboration with the aim of building AI-powered software to accelerate the drug development process and bring new drugs to market and to patients more efficiently.

PharmaRole
Pharmarole.com

Contents
Welcome to the June 2024 issue of Pharmafocus!

Comment
Considering lgbtq+ healthcare and pride month

SAMEDAN
Www.samedanltd.com
GSK invests £45m with Fleming Initiative to combat AMR
GSK has announced that it has pledged £45m to the Fleming Initiative, becoming the first founding partner of the innovative and collaborative approach to tackle antimicrobial resistance (AMR).

AstraZeneca invests $1.5bn to build ADC facility in Singapore
AstraZeneca has announced that it intends to build a $1.5bn manufacturing facility in Singapore, Singapore, for antibody drug conjugates (ADCs), with the aim of enhancing its global supply of its ADC portfolio.

Eli Lilly increases investment for manufacturing to $9bn at new Indiana site
Eli Lilly has announced that it has more than doubled its investment at its Lebanon, Indiana, US manufacturing site with a new $5.3bn investment, increasing its investment at this site to $9bn from its original $3.7bn.

Boehringer Ingelheim & OSE Immunotherapeutics to collaborate on cancer & metabolic disease treatment
OSE Immunotherapeutics and Boehringer Ingelheim have announced a major expansion of their existing partnership.

J&J’s Tremfya meets endpoints in UC study
Johnson & Johnson has announced the first data from its phase 3 QUASAR maintenance study, which assessed Tremfya (guselkumab) as a treatment for patients with moderately-to-severely active ulcerative colitis (UC).

GSK announces positive outcome from phase 3 trials for asthma treatment
GSK has announced positive headline results from its phase 3 SWIFT-1 and SWIFT-2 trials, which evaluated the safety and efficacy of Depemokimab compared to placebo in adult and adolescent patients with severe asthma with type 2 inflammation characterised by blood eosinophil count.

COMMUNIQUE
Www.pmlive.com/awards/communique/book_a_table

AstraZeneca announces data from COVID-19 prevention drug phase 3 trial
AstraZeneca has announced positive high-level results from the supernova phase 3 trial for a COVID-19 pre-exposure prophylaxis treatment, sipavibart (formerly AZD3152).

Circular Genomics shares study results predicting patient response to SSRI treatment
US RNA biomarker company Circular Genomics has announced study results highlighting the company’s first blood assay to predict a patient’s response to SSRI sertraline, with potential for SSRI class prediction overall. The assay is based on identifying brain-enriched circular RNA (circrna) biomarkers.

NIEA
Niea.pharmatimes.com

Roche’s HPV self-collection screening option approved by FDA
Roche has announced that the FDA has approved its human papillomavirus (HPV) self-collection solution.

Amgen’s Imdelltra approved by FDA for extensive-stage small cell lung cancer
Amgen has announced that the FDA has approved Imdelltra (tarlatamab-dlle) for the treatment of adult patients with extensive-stage small cell lung cancer who have had disease progression on or after platinum-based chemotherapy.

CHMP grants positive opinion for J&J’s Rybrevant for lung cancer treatment
Janssen, a Johnson & Johnson company, has announced that the CHMP of the EMA has recommended Rybrevant (amivantamab) in combination with chemotherapy.

MHRA approves Ascendis Pharma’s Yorvipath for hypoparathyroidism treatment
Ascendis Pharma has announced that the MHRA has granted marketing authorisation for Yorvipath (palopegteriparatide, developed as transcon pth) in Great Britain as a parathyroid hormone (pth) replacement therapy for the treatment of adult patients with chronic hypoparathyroidism.

PHARMATIMES
Msea.pharmatimes.com

Sanofi & Novavex sign licensing agreement to commercialise & develop COVID-19 & flu-COVID-19 vaccine
French pharma and healthcare company Sanofi and US biotech Novavex have entered into a co-exclusive licensing agreement for a number of projects, including commercialising Novavex’s covid-19 vaccine and developing a flu-covid-19 combined vaccine.

PMEA open for entry
Sales@pmlive.com

Bayer and Evotec announce collaboration for precision cardiology
Bayer and Evotec have announced that they have updated the focus of their collaboration to work on the development of innovative precision treatments for cardiovascular diseases (CVDs).

AstraZeneca and BenevolentAI add new heart failure target through collaboration
BenevolentAI has announced that AstraZeneca has added a novel heart failure target to its discovery portfolio following the two companies’ ongoing collaboration.

Beckman Coulter Life Sciences and Watchmaker Genomics to collaborate
Beckman Coulter Life Sciences and Watchmaker Genomics have announced that they have entered into a collaborative partnership with the aim of ‘deliver[ing] robust and reliable automated liquid handling solutions that enable labs to streamline operations and generate consistent results’, according to the press release.

IPT ONLINE
Www.iptonline.com website

Human Immunology Biosciences to be aquired by Biogen for $1.15bn
Biogen and Human Immunology Biosciences (HI-Bio) have announced that they have entered into a definitive agreement for Biogen to acquire HI-Bio for $1.15bn upfront, alongside up to $650m in potential milestone payments.

Mirus Bio to be acquired by Merck for $600m
Merck has announced that it has signed a definitive agreement to acquire Mirus Bio for $600m.

Nexus Pharmaceuticals’ manufacturing facility acquired by Eli Lilly
Eli Lilly and Nexus Pharmaceuticals have announced that they have entered into a definitive agreement for Eli Lilly to acquire a manufacturing facility from Nexus.

J&J ASCO 2024
Johnson & Johnson at ASCO 2024

20 years of EGFR in NSCLC: how precision medicine helps navigate lung cancer challenges
Henar Hevia at Johnson & Johnson considers the progress that has been made in lung cancer treatment since the discovery of EGFR, including the evolving treatment paradigm, the role of precision medicine in treatment decision-making and quality of life for patients receiving targeted treatments

PHARMAFOCUS
Www.pharmafocus.com

Paediatric clinical trials for obesity treatment
Alan Baldridge and Heather Peterson from ICON consider the prevalence of paediatric obesity and assess clinical trials of its treatments

Pride month and LGBTQ+ healthcare
Betsy Goodfellow from Pharmafocus considers Pride month and the state of LGBTQ+ healthcare in the UK

FLYPHARMA
Www.flypharmaeurope.com

Enhanc3D Genomics appoints Hazel Jones as CEO
Enhanc3D Genomics has announced the appointment of Hazel Jones as chief executive officer (CEO), following a successful six-month term as interim CEO and COO.

Sphere Fluidics appoints Curtis Nicholson as director of sales EMEA
Sphere Fluidics has announced the appointment of Curtis Nicholson as director for sales for Europe, Middle East and Africa (EMEA).

Closed Loop Medicine appoints Paul Johnson as non-executive director
Closed loop medicine has announced the appointment of Paul Johnson as an independent non-executive director.

Dr Alison Evans appointed head of education and training at Drug Safety Research Unit
Drug Safety Research Unit appoints Dr Alison Evans as head of education and training.

Five facts about LGBTQ+ healthcare
Five key facts about LGBTQ+ healthcare

Pharmafocus
Www.pharmafocus.com

Copy of Paediatric clinical trials for obesity treatment
